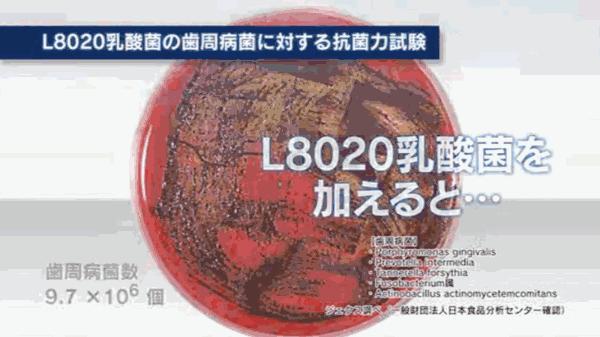
酸奶味漱口水,乳酸菌漱口水会导致蛀牙吗

从小到大,长辈常叮嘱:早晚刷牙,饭后漱口。
可清水真的太弱了。虽然能冲走牙缝里的菜叶肉丝,但口腔里还是苦苦黏黏的。
想对牙齿好,最好还是用漱口水。可以冲走食物残渣、抑制口腔细菌、立马清新口气。

日本乐可丽舒L8020乳酸菌漱口水 300ml/瓶
小编今天想推荐一款进口温和漱口水。
来自日本JEX(捷古斯)旗下,专业口腔护理品牌乐可丽舒。
JEX是日本著名的医药用品制造商。1960年成立,至今已有超过半个世纪的历史了。

乐可丽舒漱口水,堪称日本网红漱口水。
自上市以来,受到日本当地民众的疯抢,各大报纸、电视台也争相报道。
它含有一种特殊的乳酸菌——“L8020乳酸菌”。
只会抑制引起口腔异味、蛀牙虫牙、牙周疼痛的有害菌,不会伤害有益菌,不会磨损牙齿。
试验表明,杀菌率高达99.9%以上。为你赶走牙菌斑,20秒给口腔洗个澡。
适合茶、咖啡和红酒爱好者,去牙渍、防牙黄,简直是牙齿美白神器。
0酒精、不辣口、不干涩,低刺激配方,孕妇、儿童等口腔敏感人群也能用。

除了清洁、美白、温和等优点,它口感也很好。
苹果薄荷味,是春夏的味道啊!
无添加色素,澄澈如清水,入口温润不刺激,有薄荷的清凉感,就像嚼了几颗苹果味的口香糖。

漱完口,口腔内清清爽爽,吃火锅、螺蛳粉、烤串必备!大蒜、臭豆腐、韭菜,也没在怕的。
食物残留的酸臭、黏膜感完全没有了,每个牙缝死角都干干净净,就像喷了口腔清新剂!
熬夜蹦迪、喝到断片,睡前用它漱一漱,第二天早上居然一点口气都没有,服气。

换牙期儿童、常见客户商务人士、牙口不好的老人家、带牙套或不便刷牙的朋友,都很合适。
洗漱台1瓶,随身包1瓶,走到哪漱到哪,随时拥有清新口气。
1瓶300ml,少说能用2个月,一口6毛钱,20秒清新一整天。
△ 点击上方图片即可购买△

漱口水名字的由来,也颇有趣味。
世界卫生策划曾提出一个“8020”目标——80岁还能拥有20颗健康牙齿。

刚好广岛大学教授研究发现,一种对口腔有益的乳酸菌,便将其命名为“L8020乳酸菌”。
这项研究成果,在第18届日本东京科技展会上,被夸赞开创了新一代的口腔革命。

其中L8020婴幼儿护齿糖系列,还被认可为「日本齿科学校保健推荐品」,值得信赖。
“L8020乳酸菌”的清洁力,经过日本食品分析机构中心检测验证,实验数据显示:


接触齿周病菌30秒后,细菌残存率几乎为0%;
接触龋齿真菌30分钟后,真菌残存率接近0%。
注:齿周病菌,即会引起牙周疼痛、松动、出血、异味加重等的细菌。

官方还对使用者,进行后续调查研究。
连续使用7天左右,龋齿真菌就会大大减少。
细菌少了,牙菌斑和产臭菌自然也少了,口臭、蛀牙、牙周病离我们也远了。

除了L8020乳酸菌,漱口水还添加了丙三醇、木糖醇、蔗糖素、柠檬酸钠等成分。
可以优化口感、清新口气、改善口腔苦涩气味。
长期用下来,牙齿表面会形成一层保护膜,有力抵抗酸性物质的侵蚀,变得越来越健康。

既然漱口水能清洁牙齿、清新口腔,为什么还是有人不喜欢用呢?主要原因是太辣口。
为了杀菌,一些漱口水酒精含量,高达20%~30%,相当于用二锅头漱口,能不辣吗?
开车的朋友,如果上路前刚好用了,运气不好可能还会背上“酒驾”的黑锅。

但L8020乳酸菌漱口水不一样,它不含酒精。
孕妇、老人、小孩、牙齿敏感人士,都可以放心使用。哪怕有口腔溃疡,也可以用它清新口气。
非常温和,不会损伤口腔粘膜,早中晚三餐,每天用个两三次没问题的!
△ 点击上方图片即可购买△
为了更直观地表现它的清洁力,我们做了一个对比测试:

看右边吐出来的漱口水,牙缝里藏着的脏东西,都被冲刷下来了。
如果一直用这瓶漱口水,牙齿会非常健康,每年洗牙的钱都省下大几千块呢。
漱口水还成了一家七口「居家旅行必备良药」。

在公司吃完午饭,倒一瓶盖漱漱口,一下午嘴巴都清清爽爽,戴口罩也没有异味。
周末和对象约会,会偷偷把它装进包里,饭后借故上个厕所,迅速漱漱口,连接吻都是甜甜的。
面试、开会、见客户前,花20秒漱个口,不仅仪态加分,还能缓解紧张情绪。
旅行途中,汽车缺饮用水或火车用水不便,备1瓶漱口水,一切烦恼一漱了之。

我爸烟瘾大、烟味臭,每次抽完烟,漱一漱才敢进家门,妈妈再也没有发脾气。
奶奶牙口不好,容易影响胃口,自从用了漱口水,口腔不粘腻,饮食更健康了。
苹果味酸甜可口,连不爱刷牙的6岁外甥也爱上了,正是换牙关键期,特别适用,可省心了。

需要注意的是,漱口水不能代替刷牙!要保持牙齿健康,还是要好好刷牙哦!
建议搭配一支“L8020乳酸菌”同款牙膏。

蓝绿色质地,泡沫绵密细腻,也是淡淡果香气。
可以深入清洁牙渍污垢,抑菌除臭,刷完像刚刚洗过牙一样干净。

先刷牙后漱口,牙齿相当于拥有了强大的“护卫兵”,清新口气一整天。
为了80岁后,还能有一口真牙,磕得了瓜子,吃得了肉,我们一定要保护好牙齿呀!
△即可购买△
注:本文文案由品牌方提供